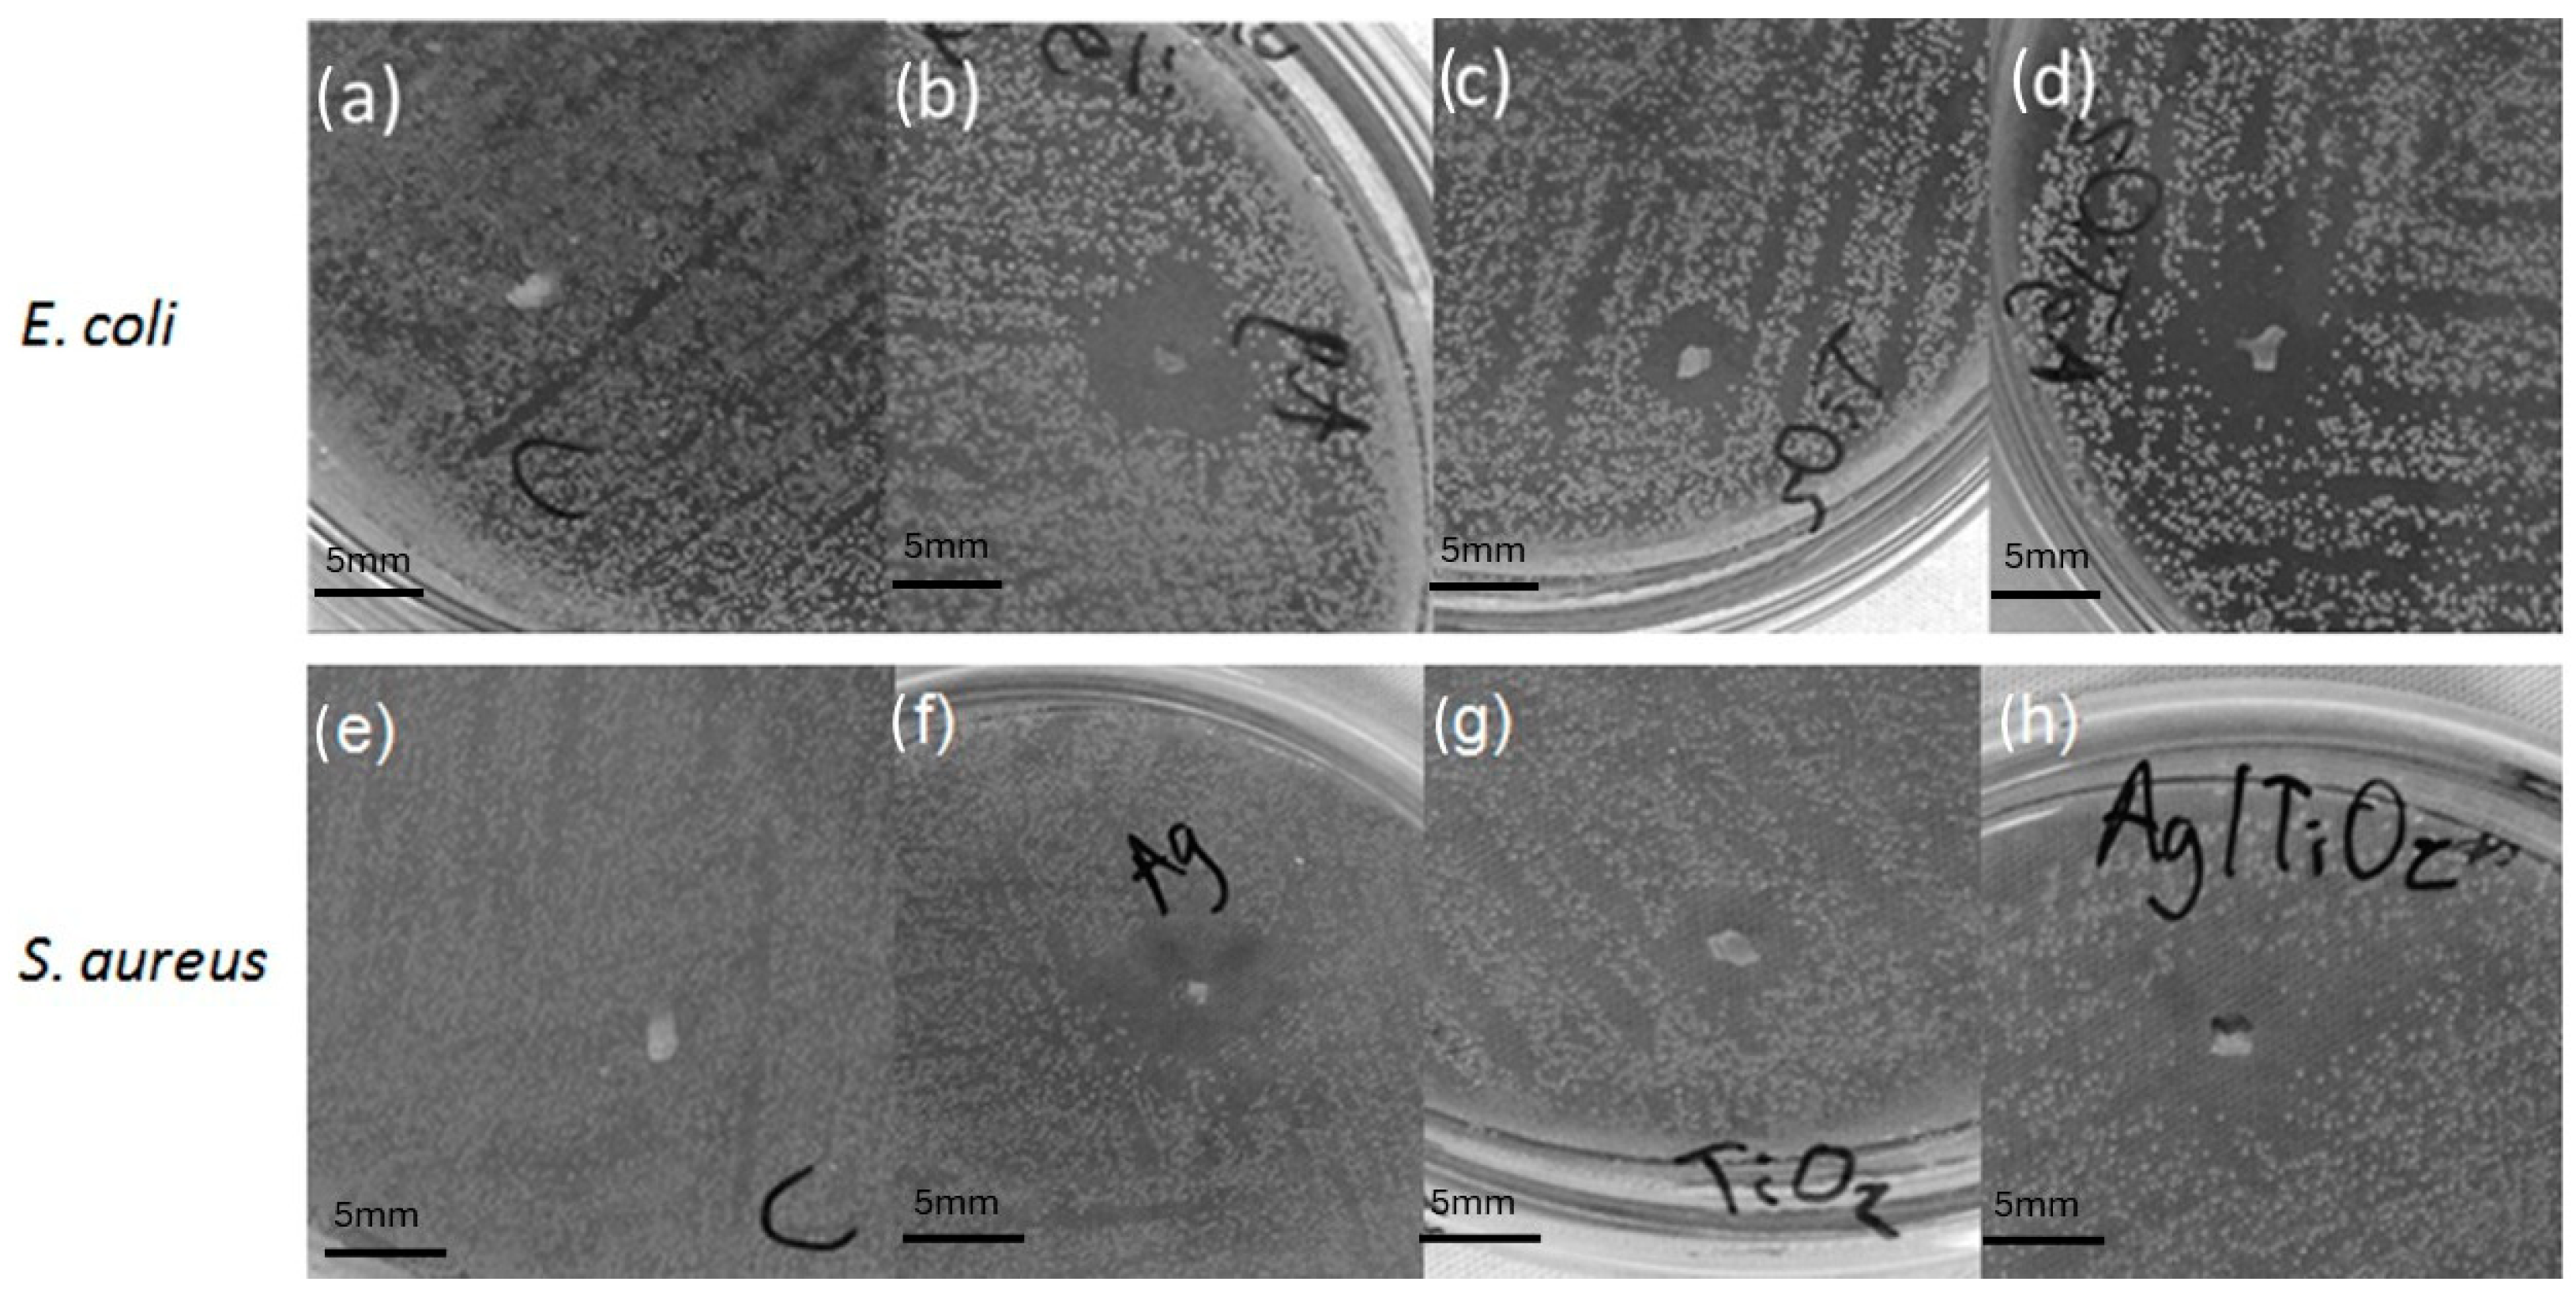
Microorganisms 12 01583 g008

Inhibition of the Growth of Escherichia coli and Staphylococcus aureus Microorganisms in Aesthetic Orthodontic Brackets through the In Situ Synthesis of Ag, TiO2 and Ag/TiO2 Nanoparticles
Abstract
1. Introduction
2. Materials and Methods
2.1. Synthesis and Incorporation of Nanoparticles in Brackets
2.1.1. Ag Nanoparticles Supported on Brackets
2.1.2. TiO2 Nanoparticles Supported on Brackets
2.1.3. Ag/TiO2 Nanoparticles Supported on Brackets
2.2. Characterization Techniques
2.3. Antibacterial Activity
3. Results and Discussion
3.1. Elemental and Superficial Characterization of the Al2O3 Bracket
3.2. Morphological Characterization of the Synthesized Nanoparticles
3.3. Characterization of the Nanoparticles Supported on the Surface of the Al2O3 Brackets
3.4. Antimicrobial Activity
4. Conclusions
Author Contributions
Funding
Data Availability Statement
Acknowledgments
Conflicts of Interest
References
- Oves, M.; Rauf, M.A.; Aslam, M.; Qari, H.A.; Sonbol, H.; Ahmad, I.; Zaman, G.S.; Saeed, M. Green synthesis of silver nanoparticles by Conocarpus Lancifolius plant extract and their antimicrobial and anticancer activities. Saudi J. Biol. Sci. 2022, 29, 460–471. [Google Scholar] [CrossRef] [PubMed]
- Kamaruzaman, N.H.; Noor, N.N.M.; Mohamed, R.M.S.R.; Al-Gheethi, A.; Ponnusamy, S.K.; Sharma, A.; Vo, D.-V.N. Applicability of bio-synthesized nanoparticles in fungal secondary metabolites products and plant extracts for eliminating antibiotic-resistant bacteria risks in non-clinical environments. Environ. Res. 2022, 209, 112831. [Google Scholar] [CrossRef] [PubMed]
- Huq, M.A.; Ashrafudoulla, M.; Rahman, M.M.; Balusamy, S.R.; Akter, S. Green synthesis and potential antibacterial applications of bioactive silver nanoparticles: A review. Polymers 2022, 14, 742. [Google Scholar] [CrossRef] [PubMed]
- Linklater, D.P.; Le Guével, X.; Bryant, G.; Baulin, V.A.; Pereiro, E.; Perera, P.G.T.; Wandiyanto, J.V.; Juodkazis, S.; Ivanova, E.P. Lethal Interactions of Atomically Precise Gold Nanoclusters and Pseudomonas aeruginosa and Staphylococcus aureus Bacterial Cells. ACS Appl. Mater. Interfaces 2022, 14, 32634–32645. [Google Scholar] [CrossRef] [PubMed]
- Bilal, M.; Zhao, Y.; Rasheed, T.; Ahmed, I.; Hassan, S.T.; Nawaz, M.Z.; Iqbal, H. Biogenic Nanoparticle–Chitosan Conjugates with Antimicrobial, Antibiofilm, and Anticancer Potentialities: Development and Characterization. Int. J. Environ. Res. Public Health 2019, 16, 598. [Google Scholar] [CrossRef] [PubMed]
- Siddiqi, K.S.; Husen, A. Properties of zinc oxide nanoparticles and their activity against microbes. Nanoscale Res. Lett. 2018, 13, 141. [Google Scholar] [CrossRef] [PubMed]
- Krishnamoorthy, R.; Athinarayanan, J.; Periyasamy, V.S.; Alshuniaber, M.A.; Alshammari, G.; Hakeem, M.J.; Ahmed, M.A.; Alshatwi, A.A. Antibacterial Mechanisms of Zinc Oxide Nanoparticle against Bacterial Food Pathogens Resistant to Beta-Lactam Antibiotics. Molecules 2022, 27, 2489. [Google Scholar] [CrossRef]
- Duan, S.; Wu, R.; Xiong, Y.-H.; Ren, H.-M.; Lei, C.; Zhao, Y.-Q.; Zhang, X.-Y.; Xu, F.-J. Multifunctional antimicrobial materials: From rational design to biomedical applications. Prog. Mater. Sci. 2022, 125, 100887. [Google Scholar] [CrossRef]
- Chatterjee, S.; Lou, X.-Y.; Liang, F.; Yang, Y.-W. Surface-functionalized gold and silver nanoparticles for colorimetric and fluorescent sensing of metal ions and biomolecules. Coord. Chem. Rev. 2022, 459, 214461. [Google Scholar] [CrossRef]
- Jia, H.; Hou, W.; Wei, L.; Xu, B.; Liu, X. The structures and antibacterial properties of nano-SiO2 supported silver/zinc–silver materials. Dent. Mater. 2008, 24, 244–249. [Google Scholar] [CrossRef]
- Marambio-Jones, C.; Hoek, E. A review of the antibacterial effects of silver nanomaterials and potential implications for human health and the environment. J. Nanoparticle Res. 2010, 12, 1531–1551. [Google Scholar] [CrossRef]
- Liu, W.; Wu, Y.; Wang, C.; Li, H.C.; Wang, T.; Liao, C.Y.; Cui, L.; Zhou, Q.F.; Yan, B.; Jiang, G.B. Impact of silver nanoparticles on human cells: Effect of particle size. Nanotoxicology 2010, 4, 319–330. [Google Scholar] [CrossRef]
- Mao, B.-H.; Luo, Y.-K.; Wang Jr, B.; Chen, C.-W.; Cheng, F.-Y.; Lee, Y.-H.; Yan, S.-J.; Wang, Y.-J. Use of an in silico knowledge discovery approach to determine mechanistic studies of silver nanoparticles-induced toxicity from in vitro to in vivo. Part. Fibre Toxicol. 2022, 19, 6. [Google Scholar] [CrossRef]
- Ji, Q.-T.; Hu, D.-K.; Mu, X.-F.; Tian, X.-X.; Zhou, L.; Yao, S.; Wang, X.-H.; Xiang, S.-Z.; Ye, H.-J.; Fan, L.-J. Cucurbit [7] uril-Mediated Supramolecular Bactericidal Nanoparticles: Their Assembly Process, Controlled Release, and Safe Treatment of Intractable Plant Bacterial Diseases. Nano Lett. 2022, 22, 4839–4847. [Google Scholar] [CrossRef]
- Wang, X.; Liu, Z.; Bani-Fwaz, M.Z.; Marzouki, R.; Ali, I.H.; El-kott, A.F.; Alhomaid, F.A. Ag nanoparticles immobilized on guanidine modified-KIT-5 mesoporous nanostructure: Evaluation of its catalytic activity for synthesis of propargylamines and investigation of its antioxidant and anti-lung cancer effects. Arab. J. Chem. 2022, 15, 103548. [Google Scholar] [CrossRef]
- Khanna, P.K.; Singh, N.; Charan, S.; Subbarao, V.; Gokhale, R.; Mulik, U.P. Synthesis and characterization of Ag/PVA nanocomposite by chemical reduction method. Mater. Chem. Phys. 2005, 93, 117–121. [Google Scholar] [CrossRef]
- Wang, H.; Qiao, X.; Chen, J.; Ding, S. Preparation of silver nanoparticles by chemical reduction method. Colloids Surf. A Physicochem. Eng. Asp. 2005, 256, 111–115. [Google Scholar] [CrossRef]
- Dizman, H.M.; Kazancioglu, E.O.; Shigemune, T.; Takahara, S.; Arsu, N. High sensitivity colorimetric determination of L-cysteine using gold nanoparticles functionalized graphene oxide prepared by photochemical reduction method. Spectrochim. Acta Part A Mol. Biomol. Spectrosc. 2022, 264, 120294. [Google Scholar] [CrossRef]
- Chen, P.; Song, L.; Liu, Y.; Fang, Y.-e. Synthesis of silver nanoparticles by γ-ray irradiation in acetic water solution containing chitosan. Radiat. Phys. Chem. 2007, 76, 1165–1168. [Google Scholar] [CrossRef]
- Attia, R.M.; Yousif, N.M.; Balboul, M.R. Facile synthesis of r GO/Ag/PVA nanocomposites polymeric films by electron beam irradiation for optoelectronic applications. Opt. Mater. 2022, 126, 112233. [Google Scholar] [CrossRef]
- Li, K.; Zhang, F.-S. A novel approach for preparing silver nanoparticles under electron beam irradiation. J. Nanoparticle Res. 2010, 12, 1423–1428. [Google Scholar] [CrossRef]
- Nthunya, L.N.; Gutierrez, L.; Mhlanga, S.D.; Richards, H.L. Bio-mediated synthesis of silver nanoparticles via conventional and irradiation-assisted methods and their application for environmental remediation in agriculture. In Green Synthesis of Silver Nanomaterials; Elsevier: Amsterdam, The Netherlands, 2022; pp. 219–239. [Google Scholar]
- Zhang, J.; Ahmadi, M.; Fargas, G.; Perinka, N.; Reguera, J.; Lanceros-Méndez, S.; Llanes, L.; Jiménez-Piqué, E. Silver Nanoparticles for Conductive Inks: From Synthesis and Ink Formulation to Their Use in Printing Technologies. Metals 2022, 12, 234. [Google Scholar] [CrossRef]
- Naganthran, A.; Verasoundarapandian, G.; Khalid, F.E.; Masarudin, M.J.; Zulkharnain, A.; Nawawi, N.M.; Karim, M.; Che Abdullah, C.A.; Ahmad, S.A. Synthesis, Characterization and Biomedical Application of Silver Nanoparticles. Materials 2022, 15, 427. [Google Scholar] [CrossRef]
- Harada, M.; Saijo, K.; Sakamoto, N. Characterization of metal nanoparticles prepared by photoreduction in aqueous solutions of various surfactants using UV–vis, EXAFS and SAXS. Colloids Surf. A Physicochem. Eng. Asp. 2009, 349, 176–188. [Google Scholar] [CrossRef]
- Abbas, A.; Amin, H.M.A. Silver Nanoparticles Modified Electrodes for Electroanalysis: An Updated Review and a Perspective. Microchem. J. 2022, 175, 107166. [Google Scholar] [CrossRef]
- Calderón-Jiménez, B.; Montoro Bustos, A.R.; Pereira Reyes, R.; Paniagua, S.A.; Vega-Baudrit, J.R. Novel pathway for the sonochemical synthesis of silver nanoparticles with near-spherical shape and high stability in aqueous media. Sci. Rep. 2022, 12, 882. [Google Scholar] [CrossRef]
- Sultan, M.; Siddique, M.; Khan, R.; Fallatah, A.M.; Fatima, N.; Shahzadi, I.; Waheed, U.; Bilal, M.; Ali, A.; Abbasi, A.M. Ligustrum lucidum Leaf Extract-Assisted Green Synthesis of Silver Nanoparticles and Nano-Adsorbents Having Potential in Ultrasound-Assisted Adsorptive Removal of Methylene Blue Dye from Wastewater and Antimicrobial Activity. Materials 2022, 15, 1637. [Google Scholar] [CrossRef]
- Barbhuiya, R.I.; Singha, P.; Asaithambi, N.; Singh, S.K. Ultrasound-assisted rapid biological synthesis and characterization of silver nanoparticles using pomelo peel waste. Food Chem. 2022, 385, 132602. [Google Scholar] [CrossRef]
- Tian, S.; Hu, Y.; Chen, X.; Liu, C.; Xue, Y.; Han, B. Green synthesis of silver nanoparticles using sodium alginate and tannic acid: Characterization and anti-S. aureus activity. Int. J. Biol. Macromol. 2022, 195, 515–522. [Google Scholar] [CrossRef]
- Zheng, M.; Wang, Z.-S.; Zhu, Y.-W. Preparation of silver nanoparticle via active template under ultrasonic. Trans. Nonferrous Met. Soc. China 2006, 16, 1348–1352. [Google Scholar] [CrossRef]
- Briones, M.A.; Altamirano, G.V.; Moreano, R.M.; Nieto, N.T. Biomateriales inteligentes usados en odontología. Arch. Venez. De Farmacol. Ter. 2022, 41, 1–7. [Google Scholar] [CrossRef]
- Estrada-Monje, A.; Zitzumbo-Guzman, R.; Banuelos-Diaz, J.A.; Zaragoza-Contreras, E.A. Ultrasonic dispersion and activation of TiO2 nanoparticles and its effect on bacterial inhibition in EVA films. Mater. Chem. Phys. 2019, 235, 121760. [Google Scholar] [CrossRef]
- Ripolles-Avila, C.; Martinez-Garcia, M.; Hascoët, A.-S.; Rodríguez-Jerez, J.J. Bactericidal efficacy of UV activated TiO2 nanoparticles against Gram-positive and Gram-negative bacteria on suspension. CyTA-J. Food 2019, 17, 408–418. [Google Scholar] [CrossRef]
- Ge, X.; Ren, C.; Ding, Y.; Chen, G.; Lu, X.; Wang, K.; Ren, F.; Yang, M.; Wang, Z.; Li, J. Micro/nano-structured TiO2 surface with dual-functional antibacterial effects for biomedical applications. Bioact. Mater. 2019, 4, 346–357. [Google Scholar] [CrossRef]
- Shang, C.; Cheung, L.M.; Ho, C.-M.; Zeng, M. Repression of photoreactivation and dark repair of coliform bacteria by TiO2-modified UV-C disinfection. Appl. Catal. B Environ. 2009, 89, 536–542. [Google Scholar] [CrossRef]
- Yan, T.; Cai, S.; Hu, Z.; Li, Z.; Fang, X. Ultrafast speed, dark current suppression, and self-powered enhancement in TiO2-based ultraviolet photodetectors by organic layers and Ag nanowires regulation. J. Phys. Chem. Lett. 2021, 12, 9912–9918. [Google Scholar] [CrossRef]
- Çeşmeli, S.; Avci, C.B. Application of titanium dioxide (TiO2) nanoparticles in cancer therapies. J. Drug Target. 2019, 27, 762–766. [Google Scholar] [CrossRef]
- Lee, H.U.; Lee, S.C.; Lee, Y.-C.; Son, B.; Park, S.Y.; Lee, J.W.; Oh, Y.-K.; Kim, Y.; Choi, S.; Lee, Y.-S. Innovative three-dimensional (3D) eco-TiO2 photocatalysts for practical environmental and bio-medical applications. Sci. Rep. 2014, 4, 6740. [Google Scholar] [CrossRef]
- Mano, S.S.; Kanehira, K.; Sonezaki, S.; Taniguchi, A. Effect of polyethylene glycol modification of TiO2 nanoparticles on cytotoxicity and gene expressions in human cell lines. Int. J. Mol. Sci. 2012, 13, 3703–3717. [Google Scholar] [CrossRef]
- Ziental, D.; Czarczynska-Goslinska, B.; Mlynarczyk, D.T.; Glowacka-Sobotta, A.; Stanisz, B.; Goslinski, T.; Sobotta, L. Titanium dioxide nanoparticles: Prospects and applications in medicine. Nanomaterials 2020, 10, 387. [Google Scholar] [CrossRef]
- Subhapriya, S.; Gomathipriya, P. Green synthesis of titanium dioxide (TiO2) nanoparticles by Trigonella foenum-graecum extract and its antimicrobial properties. Microb. Pathog. 2018, 116, 215–220. [Google Scholar] [CrossRef]
- Massima Mouele, E.S.; Dinu, M.; Cummings, F.; Fatoba, O.O.; Zar Myint, M.T.; Kyaw, H.H.; Parau, A.C.; Vladescu, A.; Francesconi, M.G.; Pescetelli, S. Effect of calcination time on the physicochemical properties and photocatalytic performance of carbon and nitrogen co-doped TiO2 nanoparticles. Catalysts 2020, 10, 847. [Google Scholar] [CrossRef]
- Bogdan, J.; Jackowska-Tracz, A.; Zarzyńska, J.; Pławińska-Czarnak, J. Chances and limitations of nanosized titanium dioxide practical application in view of its physicochemical properties. Nanoscale Res. Lett. 2015, 10, 57. [Google Scholar] [CrossRef]
- Baygi, N.J.; Saghir, A.V.; Beidokhti, S.M.; Khaki, J.V. Modified auto-combustion synthesis of mixed-oxides TiO2/NiO nanoparticles: Physical properties and photocatalytic performance. Ceram. Int. 2020, 46, 15417–15437. [Google Scholar] [CrossRef]
- Gupta, S.; Tripathi, M. A review on the synthesis of TiO2 nanoparticles by solution route. Open Chem. 2012, 10, 279–294. [Google Scholar] [CrossRef]
- Nabi, G.; Khalid, N.; Tahir, M.B.; Rafique, M.; Rizwan, M.; Hussain, S.; Iqbal, T.; Majid, A. A review on novel eco-friendly green approach to synthesis TiO2 nanoparticles using different extracts. J. Inorg. Organomet. Polym. Mater. 2018, 28, 1552–1564. [Google Scholar] [CrossRef]
- Vijayalakshmi, R.; Rajendran, V. Synthesis and characterization of nano-TiO2 via different methods. Arch. Appl. Sci. Res 2012, 4, 1183–1190. [Google Scholar]
- Bui, V.K.H.; Park, D.; Lee, Y.-C. Chitosan combined with ZnO, TiO2 and Ag nanoparticles for antimicrobial wound healing applications: A mini review of the research trends. Polymers 2017, 9, 21. [Google Scholar] [CrossRef]
- Petronella, F.; Diomede, S.; Fanizza, E.; Mascolo, G.; Sibillano, T.; Agostiano, A.; Curri, M.; Comparelli, R. Photodegradation of nalidixic acid assisted by TiO2 nanorods/Ag nanoparticles based catalyst. Chemosphere 2013, 91, 941–947. [Google Scholar] [CrossRef]
- Meydanju, N.; Pirsa, S.; Farzi, J. Biodegradable film based on lemon peel powder containing xanthan gum and TiO2–Ag nanoparticles: Investigation of physicochemical and antibacterial properties. Polym. Test. 2022, 106, 107445. [Google Scholar] [CrossRef]
- Mariappan, A.; Pandi, P.; Rajeswarapalanichamy, R.; Neyvasagam, K.; Sureshkumar, S.; Gatasheh, M.K.; Hatamleh, A.A. Bandgap and visible-light-induced photocatalytic performance and dye degradation of silver doped HAp/TiO2 nanocomposite by sol-gel method and its antimicrobial activity. Environ. Res. 2022, 211, 113079. [Google Scholar] [CrossRef]
- Ramakrishnan, V.M.; Rajesh, G.; Selvakumar, P.; Flores, M.; Muthukumarasamy, N.; Velauthapillai, D.; Chi, N.T.L.; Pugazhendhi, A. TiO2/AgO composites by one step photo reduction technique as electron transport layers (ETL) for dye-sensitized solar cells. Chemosphere 2022, 305, 134953. [Google Scholar] [CrossRef]
- Butmee, P.; Samphao, A.; Tumcharern, G. Reduced graphene oxide on silver nanoparticle layers-decorated titanium dioxide nanotube arrays as SERS-based sensor for glyphosate direct detection in environmental water and soil. J. Hazard. Mater. 2022, 437, 129344. [Google Scholar] [CrossRef]
- Argueta-Figueroa, L.; Morales-Luckie, R.A.; Scougall-Vilchis, R.J.; Olea-Mejía, O.F. Synthesis, characterization and antibacterial activity of copper, nickel and bimetallic Cu–Ni nanoparticles for potential use in dental materials. Prog. Nat. Sci. Mater. Int. 2014, 24, 321–328. [Google Scholar] [CrossRef]
- Hernández-Gómora, A.E.; Lara-Carrillo, E.; Robles-Navarro, J.B.; Scougall-Vilchis, R.J.; Hernández-López, S.; Medina-Solís, C.E.; Morales-Luckie, R.A. Biosynthesis of silver nanoparticles on orthodontic elastomeric modules: Evaluation of mechanical and antibacterial properties. Molecules 2017, 22, 1407. [Google Scholar] [CrossRef]
- Argueta-Figueroa, L.; Scougall-Vilchis, R.J.; Morales-Luckie, R.A.; Olea-Mejía, O.F. An evaluation of the antibacterial properties and shear bond strength of copper nanoparticles as a nanofiller in orthodontic adhesive. Australas. Orthod. J. 2015, 31, 42–48. [Google Scholar] [CrossRef]
- Garcia-Contreras, R.; Scougall-Vilchis, R.J.; Contreras-Bulnes, R.; Sakagami, H.; Morales-Luckie, R.A.; Nakajima, H. Mechanical, antibacterial and bond strength properties of nano-titanium-enriched glass ionomer cement. J. Appl. Oral Sci. 2015, 23, 321–328. [Google Scholar] [CrossRef]
- Bauer, A. Antibiotic susceptibility testing by a standardized single disc method. Am. J. Clin. Pathol. 1966, 45, 149–158. [Google Scholar] [CrossRef]
- Tholen, D.W.; Linnet, K.; Kondratovich, M.; Armbruster, D.A.; Garrett, P.E.; Jones, R.L.; Kroll, M.H.; Lequin, R.M.; Pankratz, T.J.; Scassellati, G. Protocols for determination of limits of detection and limits of quantitation; approved guideline. CLSI EP17-A 2004, 24, 34. [Google Scholar]
- Khojasteh, F.; Mersagh, M.R.; Hashemipour, H. The influences of Ni, Ag-doped TiO2 and SnO2, Ag-doped SnO2/TiO2 nanocomposites on recombination reduction in dye synthesized solar cells. J. Alloys Compd. 2022, 890, 161709. [Google Scholar] [CrossRef]
- Zhang, H.; Chen, G. Potent antibacterial activities of Ag/TiO2 nanocomposite powders synthesized by a one-pot sol− gel method. Environ. Sci. Technol. 2009, 43, 2905–2910. [Google Scholar] [CrossRef] [PubMed]
- Atarod, M.; Nasrollahzadeh, M.; Sajadi, S.M. Euphorbia heterophylla leaf extract mediated green synthesis of Ag/TiO2 nanocomposite and investigation of its excellent catalytic activity for reduction of variety of dyes in water. J. Colloid Interface Sci. 2016, 462, 272–279. [Google Scholar] [CrossRef] [PubMed]
- Akhavan, O.; Ghaderi, E. Self-accumulated Ag nanoparticles on mesoporous TiO2 thin film with high bactericidal activities. Surf. Coat. Technol. 2010, 204, 3676–3683. [Google Scholar] [CrossRef]
- Ashkarran, A. Antibacterial properties of silver-doped TiO2 nanoparticles under solar simulated light. J. Theor. Appl. Phys. 2011, 4, 1–8. [Google Scholar]
- Tunc, I.; Bruns, M.; Gliemann, H.; Grunze, M.; Koelsch, P. Bandgap determination and charge separation in Ag@ TiO2 core shell nanoparticle films. Surf. Interface Anal. 2010, 42, 835–841. [Google Scholar] [CrossRef]
- Massaro, C.; Rotolo, P.; De Riccardis, F.; Milella, E.; Napoli, A.; Wieland, M.; Textor, M.; Spencer, N.; Brunette, D. Comparative investigation of the surface properties of commercial titanium dental implants. Part I: Chemical composition. J. Mater. Sci. Mater. Med. 2002, 13, 535–548. [Google Scholar] [CrossRef] [PubMed]
- Györgyey, Á.; Janovak, L.; Adam, A.; Kopniczky, J.; Tóth, K.L.; Deák, Á.; Panayotov, I.; Cuisinier, F.; Dékány, I.; Turzo, K. Investigation of the in vitro photocatalytic antibacterial activity of nanocrystalline TiO2 and coupled TiO2/Ag containing copolymer on the surface of medical grade titanium. J. Biomater. Appl. 2016, 31, 55–67. [Google Scholar] [PubMed]
- Liu, N.; Zhu, Q.; Zhang, N.; Zhang, C.; Kawazoe, N.; Chen, G.; Negishi, N.; Yang, Y. Superior disinfection effect of Escherichia coli by hydrothermal synthesized TiO2-based composite photocatalyst under LED irradiation: Influence of environmental factors and disinfection mechanism. Environ. Pollut. 2019, 247, 847–856. [Google Scholar] [CrossRef] [PubMed]
- Xu, X.; Wu, C.; Guo, A.; Qin, B.; Sun, Y.; Zhao, C.; Zhang, F.; Cai, A. Visible-light photocatalysis of organic contaminants and disinfection using biomimetic-synthesized TiO2-Ag-AgCl composite. Appl. Surf. Sci. 2022, 588, 152886. [Google Scholar] [CrossRef]
- Deng, K.; Li, Y.; Liang, X.; Shen, C.; Zeng, Z.; Xu, X. Virus-inspired nanoparticles as versatile antibacterial carriers for antibiotic delivery against Gram-negative and Gram-positive bacteria. Chin. Chem. Lett. 2022, 33, 1619–1622. [Google Scholar] [CrossRef]
- Kong, J.; Zhang, S.; Shen, M.; Zhang, J.; Yoganathan, S. Evaluation of copper (I)-doped zinc oxide composite nanoparticles on both gram-negative and gram-positive bacteria. Colloids Surf. A Physicochem. Eng. Asp. 2022, 643, 128742. [Google Scholar] [CrossRef]
- Su, J.; Li, H.; Hu, J.; Wang, D.; Zhang, F.; Fu, Z.; Han, F. LcCCL28-25, Derived from Piscine Chemokine, Exhibits Antimicrobial Activity against Gram-Negative and Gram-Positive Bacteria In Vitro and In Vivo. Microbiol. Spectr. 2022, 10, e02515-21. [Google Scholar] [CrossRef]
- Karami, A.; Xie, Z.; Zhang, J.; Kabir, M.S.; Munroe, P.; Kidd, S.; Zhang, H. Insights into the antimicrobial mechanism of Ag and I incorporated ZnO nanoparticle derivatives under visible light. Mater. Sci. Eng. C 2020, 107, 110220. [Google Scholar] [CrossRef]
- Li, M.; Noriega-Trevino, M.E.; Nino-Martinez, N.; Marambio-Jones, C.; Wang, J.; Damoiseaux, R.; Ruiz, F.; Hoek, E.M. Synergistic bactericidal activity of Ag-TiO2 nanoparticles in both light and dark conditions. Environ. Sci. Technol. 2011, 45, 8989–8995. [Google Scholar] [CrossRef]
- Espinosa-Cristóbal, L.F.; López-Ruiz, N.; Cabada-Tarín, D.; Reyes-López, S.Y.; Zaragoza-Contreras, A.; Constandse-Cortéz, D.; Donohué-Cornejo, A.; Tovar-Carrillo, K.; Cuevas-González, J.C.; Kobayashi, T. Antiadherence and antimicrobial properties of silver nanoparticles against Streptococcus mutans on brackets and wires used for orthodontic treatments. J. Nanomater. 2018, 2018, 9248527. [Google Scholar] [CrossRef]
- Cao, S.; Liu, B.; Fan, L.; Yue, Z.; Liu, B.; Cao, B. Highly antibacterial activity of N-doped TiO2 thin films coated on stainless steel brackets under visible light irradiation. Appl. Surf. Sci. 2014, 309, 119–127. [Google Scholar] [CrossRef]

| Diameter of Inhibition Halos (mm) | ||||
|---|---|---|---|---|
| Strain | Control | Ag | TiO2 | Ag/TiO2 |
| S. aureus | NP | 8.8 ± 0.3 | 6.0 ± 0.6 | 8.7 ± 0.8 |
| E. coli | NP | 8.3 ± 0.2 | 5.0 ± 0.3 | 8.9 ± 0.1 |
Disclaimer/Publisher’s Note: The statements, opinions and data contained in all publications are solely those of the individual author(s) and contributor(s) and not of MDPI and/or the editor(s). MDPI and/or the editor(s) disclaim responsibility for any injury to people or property resulting from any ideas, methods, instructions or products referred to in the content. |
© 2024 by the authors. Licensee MDPI, Basel, Switzerland. This article is an open access article distributed under the terms and conditions of the Creative Commons Attribution (CC BY) license (https://creativecommons.org/licenses/by/4.0/).
Share and Cite
Sánchez Reyna, P.A.; Olea Mejía, O.F.; González-Pedroza, M.G.; Montiel-Bastida, N.M.; Rebollo-Plata, B.; Morales-Luckie, R.A. Inhibition of the Growth of Escherichia coli and Staphylococcus aureus Microorganisms in Aesthetic Orthodontic Brackets through the In Situ Synthesis of Ag, TiO2 and Ag/TiO2 Nanoparticles. Microorganisms 2024, 12, 1583. https://doi.org/10.3390/microorganisms12081583
Sánchez Reyna PA, Olea Mejía OF, González-Pedroza MG, Montiel-Bastida NM, Rebollo-Plata B, Morales-Luckie RA. Inhibition of the Growth of Escherichia coli and Staphylococcus aureus Microorganisms in Aesthetic Orthodontic Brackets through the In Situ Synthesis of Ag, TiO2 and Ag/TiO2 Nanoparticles. Microorganisms. 2024; 12(8):1583. https://doi.org/10.3390/microorganisms12081583
Chicago/Turabian StyleSánchez Reyna, Paola Ariselda, Oscar Fernando Olea Mejía, María G. González-Pedroza, Norma M. Montiel-Bastida, Bernabe Rebollo-Plata, and Raúl A. Morales-Luckie. 2024. "Inhibition of the Growth of Escherichia coli and Staphylococcus aureus Microorganisms in Aesthetic Orthodontic Brackets through the In Situ Synthesis of Ag, TiO2 and Ag/TiO2 Nanoparticles" Microorganisms 12, no. 8: 1583. https://doi.org/10.3390/microorganisms12081583
APA StyleSánchez Reyna, P. A., Olea Mejía, O. F., González-Pedroza, M. G., Montiel-Bastida, N. M., Rebollo-Plata, B., & Morales-Luckie, R. A. (2024). Inhibition of the Growth of Escherichia coli and Staphylococcus aureus Microorganisms in Aesthetic Orthodontic Brackets through the In Situ Synthesis of Ag, TiO2 and Ag/TiO2 Nanoparticles. Microorganisms, 12(8), 1583. https://doi.org/10.3390/microorganisms12081583

